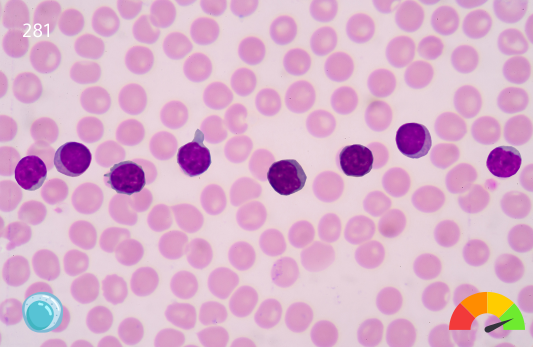
CD3/CD4 Test

تفاصيل التحليل
تحليل نسبة خلايا (CD3/CD4)
تحليل يقيس مستويات الخلايا التائية المساعدة (CD4)، وهو مؤشر حيوي لقوة الدفاع المناعي ضد العدوى، ويستخدم لمتابعة حالات نقص المناعة وضمان فعالية البروتوكولات العلاجية.
الصورة التوضيحية المرتبطة بهذا التحليل